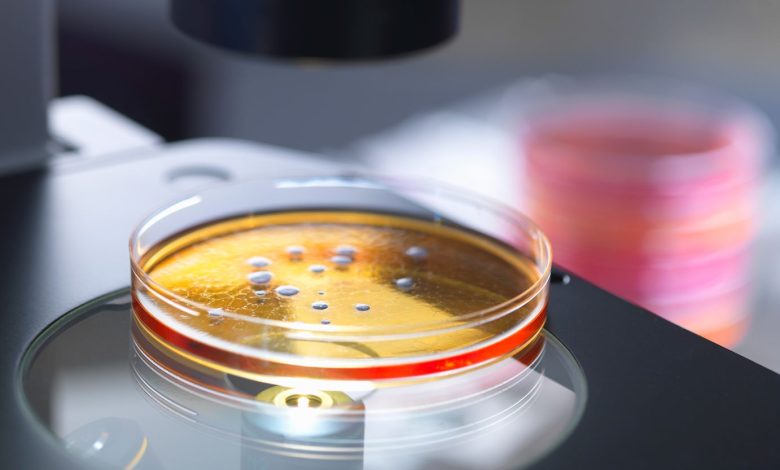

Bilim dünyasında “ayna yaşam” endişesi
Bilim insanları, laboratuvar ortamında “ayna hücre” üretme çalışmalarının kontrolden çıkması halinde doğadaki tüm yaşam formlarını tehdit edebileceği uyarısında bulundu.
Dünya genelinde yankı uyandıran bir bilimsel tartışma büyüyor. Bazı araştırmacılar, laboratuvar ortamında geliştirilen ve tüm biyomolekülleri doğadakilerin tam tersi biçimde yapılandırılmış “ayna hücreler”in, insanlık tarihinin en büyük biyolojik riski haline gelebileceğini savunuyor.
Bu hücreler, yaşamın kökenini anlamaya yardımcı olabilirken, aynı zamanda bağışıklık sistemi tarafından algılanamayan yeni türde organizmaların ortaya çıkmasına da yol açabilir.
Teoriden tehlikeye
Ayna hücre kavramı, tüm moleküler yapının doğadaki canlıların tam tersi yönlü kopyası olarak tanımlanıyor. Normal hücrelerde DNA sağ elli, proteinler ise sol ellidir. Bu özellik, yaşamın temel taşı olan “kiralite” olarak bilinir. Ancak bu yönün tamamen tersine çevrilmesiyle, doğada hiç var olmamış bir yaşam formu elde edilebilir.
Başlangıçta bu çalışmalar, yeni tedavi yöntemleri ve dirençli moleküller geliştirme amacı taşıyordu. Ancak bilim insanları, böyle bir hücrenin laboratuvardan sızması durumunda bağışıklık sisteminin bu organizmayı tanıyamayacağını ve durduramayacağını fark etti.
Bilim dünyasında bölünme
Kimi araştırmacılar, bu tür hücrelerin çevreye yayılarak doğal dengeyi bozabileceğini ve “ters biyolojik zincir” oluşturabileceğini savunuyor. Diğerleri ise endişelerin abartıldığını, çünkü bu hücrelerin yaşamını sürdürebilmesi için son derece özel koşullar gerektiğini belirtiyor.
Bazı uzmanlara göre, laboratuvar ortamında üretilecek bir ayna bakterisi, doğal organizmalarla etkileşime girmesi halinde ekosistemleri çökertme potansiyeline sahip olabilir. Buna karşın, pek çok bilim insanı henüz böyle bir hücrenin üretilmesinin mümkün olmadığını, ancak önümüzdeki birkaç on yıl içinde bunun değişebileceğini kabul ediyor.
“Yaşamın karanlık yansıması”
Bilim insanlarının uyarılarına göre, bir ayna hücre varlık kazanırsa bu organizmalar doğal biyolojik denetim mekanizmalarına karşı görünmez hale gelebilir.
Antibiyotikler, enzimler ve bağışıklık sistemi bile bu hücreleri tanımlayamayabilir. Böyle bir senaryoda, yeni tür bir enfeksiyon zinciri veya biyolojik çöküş yaşanabilir.
Bazı uzmanlar bu olasılığı “biyolojik kıyamet senaryosu” olarak nitelendiriyor. Laboratuvar güvenlik önlemleriyle bile insan hatası veya kötü niyetli kullanım riskinin tamamen ortadan kaldırılamayacağı ifade ediliyor.
Bilimsel etik ve kırmızı çizgiler
Bu tartışmaların ardından, birçok araştırma grubu ayna hücre üretiminden gönüllü olarak vazgeçti. Ancak kimileri, tamamen yasaklama çağrısının bilimin ilerlemesini durduracağını savunuyor.
Bazı biyokimyacılar, ayna moleküllerin ilaç geliştirmede önemli bir rol oynayabileceğini, çünkü bu moleküllerin vücutta daha uzun süre dayanabildiğini vurguluyor.
Buna rağmen, geniş bir bilim çevresi, canlı ayna hücrelerin üretilmemesi gerektiğinde hemfikir. Uzmanlar, uluslararası düzeyde açık sınırların belirlenmesi ve gelecekte bu teknolojinin kötüye kullanılmaması için küresel denetim mekanizmaları oluşturulmasını öneriyor.
Yeni bir dönüm noktası mı?
Tartışmalar sürerken, bilim dünyası büyük bir ikilemin ortasında: Bir yanda yaşamın sırlarını çözme umudu, diğer yanda insanlığın kendi sonunu hazırlama ihtimali.
Ayna hücrelerin gerçekten üretilebileceği gün geldiğinde, bilim insanlarının önünde tek bir soru kalacak: “Yapabiliyoruz ama yapmalı mıyız?”